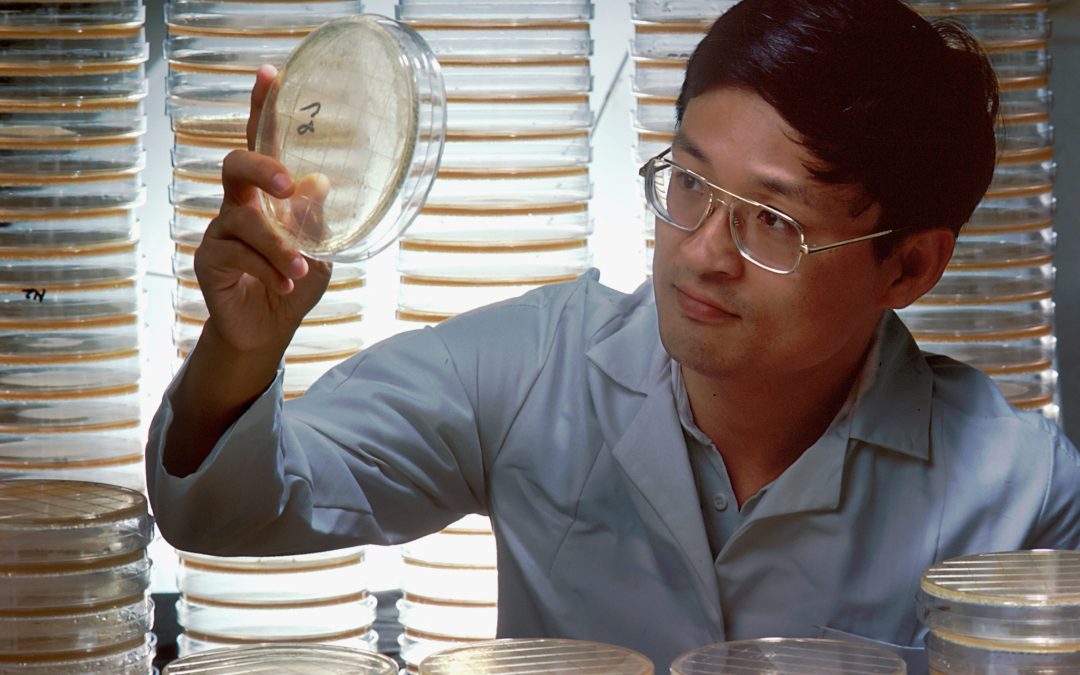

Who is a scientist?
The term “scientist” is a relatively modern construct, born out of centuries of intellectual and philosophical evolution. The journey to define the identity of a scientist spans diverse historical contexts, reflecting the changing perceptions of knowledge, empirical inquiry, and the scientific method.
Ancient Philosophers and Natural Philosophers:
In the ancient world, the boundaries between what we now call science, philosophy, and natural philosophy (a precursor to science) were blurred. Philosophers like Aristotle and Pythagoras engaged in systematic inquiries into the natural world, seeking explanations for various phenomena. They laid the groundwork for empirical observation and rational thinking, but the pursuit of knowledge during this period was not confined to the realm of specialised scientists.
Medieval Scholars and the Emergence of Universities:
During the Middle Ages, the pursuit of knowledge shifted from individual philosophers to centers of learning known as universities. These institutions brought together scholars from diverse fields, including theology, philosophy, and the natural sciences. However, the distinction between what constituted a “scientist” and other scholars remained nebulous, with no specific designation for those dedicated solely to scientific pursuits.
The Scientific Revolution and the Rise of Modern Science:
The 16th and 17th centuries marked a transformative period known as the Scientific Revolution. Visionary figures like Nicolaus Copernicus, Galileo Galilei, Johannes Kepler, and Isaac Newton broke away from traditional dogma and embraced empirical experimentation and mathematical principles. The systematic application of the scientific method, along with the formulation of natural laws, heralded the emergence of modern science.
The Birth of the Term “Scientist”:
The term “scientist” itself was coined in the 19th century by Reverend William Whewell. He introduced it to distinguish those who pursued scientific inquiries from artists and philosophers. Previously, individuals conducting scientific investigations were referred to as “natural philosophers,” a term dating back to ancient times. The introduction of the term “scientist” marked a significant shift in how society perceived and classified those dedicated to the study of nature and the natural world.
Specialisation and Professionalisation of Science:
As scientific knowledge expanded and diversified, so did the number of scientific disciplines. The 19th and 20th centuries witnessed the professionalization of science, with researchers becoming increasingly specialized in their fields of study. The scientific community evolved, embracing rigorous education, peer-reviewed publications, and formal institutions dedicated to scientific research and education.
Contemporary Notions of a Scientist:
In the 21st century, the identity of a scientist is shaped by a combination of education, research, and engagement with society. Scientists are professionals with advanced degrees, working in academia, industry, government, or non-profit organizations. They are committed to the pursuit of empirical knowledge, employing the scientific method to answer questions and solve problems. Moreover, modern scientists are not only specialists in their fields but also collaborators across disciplines, recognizing the interconnectedness of scientific knowledge.
Conclusion:
The concept of a scientist has evolved significantly throughout history, from the natural philosophers of ancient times to the specialized professionals of today. The journey to define the identity of a scientist reflects the changing nature of human inquiry, intellectual pursuits, and societal values. As we continue to explore the natural world and unravel its mysteries, the role of the scientist remains pivotal, driving progress, innovation, and our collective understanding of the universe.

